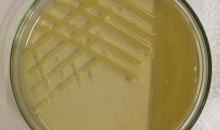
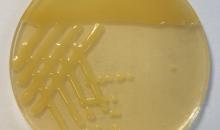

Xanthomonas phaseoli pv. phaseoli(XANTPH)
Photos
All photos included on this page can only be used for educational purposes.
For publication in journals, books or magazines, permission should be obtained from the original photographers with a copy to EPPO.
For publication in journals, books or magazines, permission should be obtained from the original photographers with a copy to EPPO.
Morphology and colony characteristics of Xanthomonas phaseoli pv. phaseoli on YPGA medium.
Courtesy: Ebrahim Osdaghi
Morphology and colony characteristics of Xanthomonas phaseoli pv. phaseoli on YPGA medium.
Courtesy: Ebrahim Osdaghi
Typical circular, slightly depressed dark red-brown lesions on a bean pod.
Courtesy: Marie-Agnès Jacques (IRHS, FR)
Typical dry and brown necrotic lesions surrounded by a narrow yellow halo on a bean leaflet.
Courtesy: Marie-Agnès Jacques (IRHS, FR)
Symptoms on Phaseolus vulgaris; note yellow halo around lesions.
Courtesy: V.R. Wallen, Agriculture Canada (CA).














